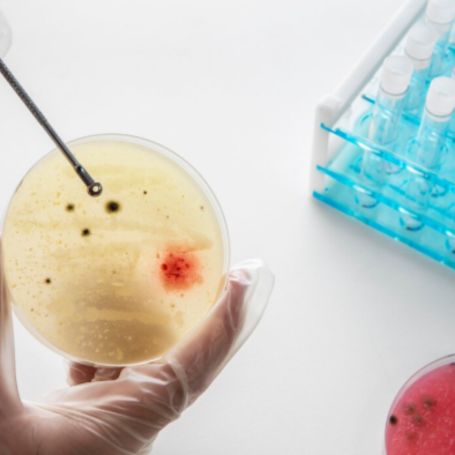

At Diagnopein Diagnostic Centre Nashik, the histone antibody test is performed using modern laboratory techniques to measure anti-histone IgG levels in the blood. The report helps rheumatologists a


Histone antibodies, also called anti-histone antibodies, are abnormal immune proteins that mistakenly attack histone proteins present in the nucleus of cells. These autoantibodies are strongly associated with autoimmune diseases, especially drug-induced lupus and some cases of systemic lupus. When a patient develops symptoms like joint pain, fatigue, skin rashes or photosensitivity, a histone antibody test in Nashik at Diagnopein can help doctors evaluate the possibility of an underlying autoimmune condition.
Why Histone Antibodies Testing Is Important
The histone antibody test is particularly important when your doctor suspects drug-induced lupus due to long-term use of certain medications. Many commonly used drugs can trigger autoimmune reactions and cause anti-histone antibodies to form. In such cases, a positive histone antibody test at Diagnopein Nashik supports the diagnosis and helps guide further management.
reasons why histone antibodytesting is important at Diagnopein Diagnostic Centre Nashik:
Helps differentiate drug-induced lupus from systemic lupus erythematosus.
Complements ANA test, anti-dsDNA test and other autoimmune disease tests.
Useful when patients present with lupus-like symptoms and are on high-risk medications.
Supports early diagnosis so that the suspected drug can be stopped or modified in time.
For patients in Nashik, combining the histone antibody test with ANA test, anti-dsDNA and ENA panel at Diagnopein provides a comprehensive autoimmune profile. This approach is ideal for anyone searching terms like “autoimmune disease test Nashik,” “lupus blood test Nashik,” or “ANA test near me.”
Choosing the right diagnostic centre is crucial for sensitive tests such as histone antibodies. Diagnopein Diagnostic Centre in Nashik focuses on quality, accuracy and patient comfort while performing all autoimmune blood tests.
Main benefits of doing the histone antibody test at Diagnopein Nashik:
Advanced technology: The anti-histone IgG test is done using standardized immunoassay methods for reliable results.
Expert team: Experienced pathologists and lab technologists review every histone antibody test report for accuracy.
Fast turnaround time: Patients in Nashik receive prompt online reports, helping doctors take quick treatment decisions.
Affordable pricing: Competitive pricing for histone antibody test Nashik, making advanced autoimmune testing accessible.
Integrated testing: Facility to combine histone antibody test with ANA, anti-dsDNA, CRP, ESR and other relevant parameters.
Patients who look for “best diagnostic centre Nashik,” “pathology lab in Nashik,” or “Diagnopein Nashik autoimmune test” can trust Diagnopein Diagnostic Centre for consistent and high-quality lab services.
The histone antibody test at Diagnopein Nashik is a simple blood test that does not require fasting in most cases. The process is quick, safe and handled by trained phlebotomists.
Step-by-step process at Diagnopein Diagnostic Centre Nashik:
Sample collection: A blood sample is collected from a vein in your arm at the Nashik centre or through home collection if available in your area.
Laboratory testing: The serum is separated and analyzed for anti-histone antibodies (usually IgG type) using a validated testing kit.
Result interpretation: The report usually provides results as negative or positive, sometimes with a quantitative value. Your doctor will interpret the histone antibody test along with your symptoms and other reports.
Follow-up testing: If required, your doctor may also advise ANA test, anti-dsDNA, ENA panel, rheumatoid factor or other autoimmune disease tests at Diagnopein Nashik.
Before the test, patients should inform their doctor and the Diagnopein Nashik team about ongoing medicines, as some drugs can influence autoantibody levels. By keeping the process clear and transparent, Diagnopein Diagnostic Centre Nashik ensures a smooth experience for both patients and doctors.
In a typical histone antibody test report from Diagnopein Diagnostic Centre Nashik, the main parameter is:
Anti-histone antibody (IgG) – reported as negative or positive, and sometimes as a numerical value with a reference range.
A negative histone antibody result generally suggests that autoantibodies against histones are not detected at significant levels. A positive result indicates the presence of anti-histone antibodies and may point toward drug-induced lupus or another autoimmune disorder, depending on the clinical context. Your doctor may correlate the histone antibody test with ANA, anti-dsDNA and clinical findings before confirming the diagnosis.
Diagnopein Diagnostic Centre in Nashik is a trusted name for blood tests, autoimmune profiles and specialized pathology investigations. For patients searching for “histone antibody test Nashik,” “anti histone antibodies test Nashik,” or “diagnostic center in Nashik,” Diagnopein offers:
Convenient location in Nashik with easy access and comfortable sample collection.
Trained staff, hygienic setup and patient-centric service.
Option to book tests online or through phone for added convenience.
Reliable reports that help doctors confidently manage autoimmune diseases.
If you need a histone antibody test, ANA test or any other autoimmune disease test in Nashik, you can book your appointment at Diagnopein Diagnostic Centre Nashik and take a proactive step towards better health.
The risks associated with the histone antibody test are minimal, similar to any routine blood test. You may experience slight bruising, discomfort, or dizziness at the blood draw site, but these symptoms typically resolve quickly.
No special preparation is required before a test of histone antibody. However, you should inform your healthcare provider about any medications you are taking, as certain drugs may influence the results.
This test is typically ordered if your doctor suspects you may have an autoimmune condition, especially drug-induced lupus. It helps in diagnosing and differentiating lupus types and other related autoimmune disorders.
Symptoms like fatigue, joint pain, skin rashes, and sensitivity to sunlight may lead your doctor to recommend a histone antibody test, especially if they suspect an autoimmune disease like lupus.